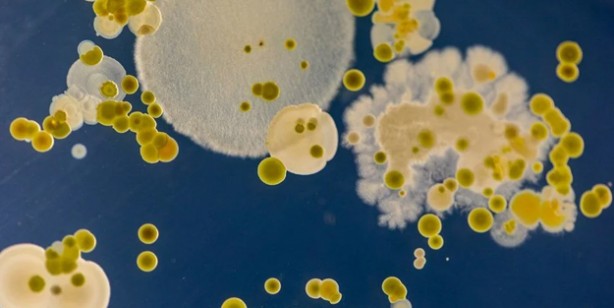
Foto - Mumya geri döndü! Hareket eden cesedi gören uzmanlardan 'sakın yaklaşmayın' uyarısı: Tehlike saçıyor!

Mumya geri döndü! Hareket eden cesedi gören uzmanlardan 'sakın yaklaşmayın' uyarısı: Tehlike saçıyor!
Meksika'da Milli Tarih ve Antropoloji Müzesi'nde sergilenen eski mumyaların üzerinde oluşan mikroorganizmalar bir nevi tepki gösterdi, şaşırtan anlar yaşandı. Hareket eden cesedi gören yetkililer apar topar telefona sarıldı. Araştırmacılar bile bu işe şaştı kaldı! Bu ilginç olay Antik Mısır'daki benzerlerinin aksine bir ritüel sonucu değil, Guanajuato bölgesinin kuru, mineral açısından zengin topraklarında gömülen insanlardan oluştuğu öne sürüldü. Bu nedenle mantarın yayılma ihtimalinin olduğu iddia edildi. Üzerinde oluşan mikroorganizmalar sebebiyle halk sağlığını tehdit ettiği açıklandı. Detayları böle duyurdular...